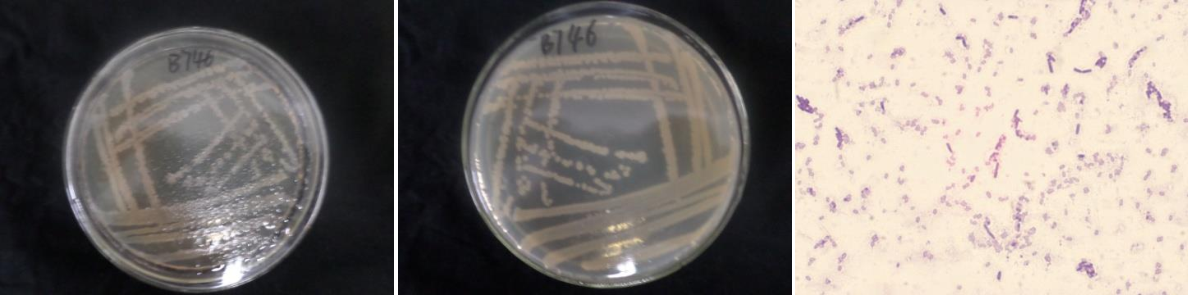

Loading...
| StrainNO | B746 |
| Classification | Bacillus |
| 16s rDNA sequence | AGGGGCGGCGTGCCTAATACATGCAAGTCGAGCGGAGTTTTGAAAAGCTTGCTTTTCAAAACTTAGCGGCGGACGGGTGAGTAA CACGTGGGCAACCTGCCCTTGAGACGGGGATAACTCCGGGAAACCGGAGCTAATACCGGATAACACATATCTTCGCATGAGGAT ATGTTAGAAGGTGGCTTTTAGCTACCACTCAAGGATGGGCCCGCGGCGCATTAGCTAGTTGGTGAGGTAACGGCTCACCAAGGC GACGATGCGTAGCCGACCTGAGAGGGTGATCGGCCACACTGGGACTGAGACACGGCCCAGACTCCTACGGGAGGCAGCAGTAGG GAATCTTCCGCAATGGACGAAAGTCTGACGGAGCAACGCCGCGTGAGTGATGAAGGTTTTCGGATCGTAAAGCTCTGTTGTTAG GGAAGAACAAGTACCTGTTAAATAAGCAGGTACCTTGACGGTACCTAACCAGAAAGCCACGGCTAACTACGTGCCAGCAGCCGC GGTAATACGTAGGTGGCAAGCGTTGTCCGGAATTATTGGGCGTAAAGCGCGCGCAGGCGGTTCCTTAAGTCTGATGTGAAAGCC CACGGCTCAACCGTGGAGGGTCATTGGAAACTGGGGAACTTGAGTGCAGAAGAGGAGAGCGGAATTCCACGTGTAGCGGTGAAA TGCGTAGAGATGTGGAGGAACACCAGTGGCGAAGGCGGCTCTCTGGTCTGTAACTGACGCTGAGGCGCGAAAGCGTGGGGAGCG AACAGGATTAGATACCCTGGTAGTCCACGCCGTAAACGATGAGTGCTAAGTGTTAGAGGGTTTCCGCCCTTTAGTGCTGCAGCA AACGCATTAAGCACTCCGCCTGGGGAGTACGGTCGCAAGACTGAAACTCAAAGGAATTGACGGGGACCCGCACAAGCGGTGGAG CATGTGGTTTAATTCGAAGCAACGCGAAGAACCTTACCAGGTCTTGACATCCTCTGCTACTTCTAGAGATAGAAGGTTCCCTTC GGGGACAGAGTGACAGGTGGTGCATGGTTGTCGTCAGCTCGTGTCGTGAGATGTTGGGTTAAGTCCCGCAACGAGCGCAACCCTTGATCTTAGTTGCCAGCATTCAGTTGGGCACTCTAAGGTGACTGCCGGTGACAAACCGGAGGAAGGTGGGGATGACGTCAAATC ATCATGCCCCTTATGACCTGGGCTACACACGTGCTACAATGGATGGTACAAAGGGCTGCAAAACCGCGAGGTTAAGCCAATCCC ATAAAACCATTCTCAGTTCGGATTGTAGGCTGCAACTCGCCTACATGAAGCCGGAATCGCTAGTAATCGCGGATCAGCATGCCG CGGTGAATACGTTCCCGGGTCTTGTACACACCGCCCGTCACACCACGAGAGTTTGTAACACCCGAAGTCGGTGAGGTAACCTTT TGGAGCCAGCCGCCGAAGGTGGACAGAGGT |
| Strain Morphology Photos | |
| Morphological Description | The morphology of Colony round;clam white;edge serrated;concentric ring;wrinkled;slippy;sticky;waxy;The morphology of strain:Rod;having spore;bias in budding spores |